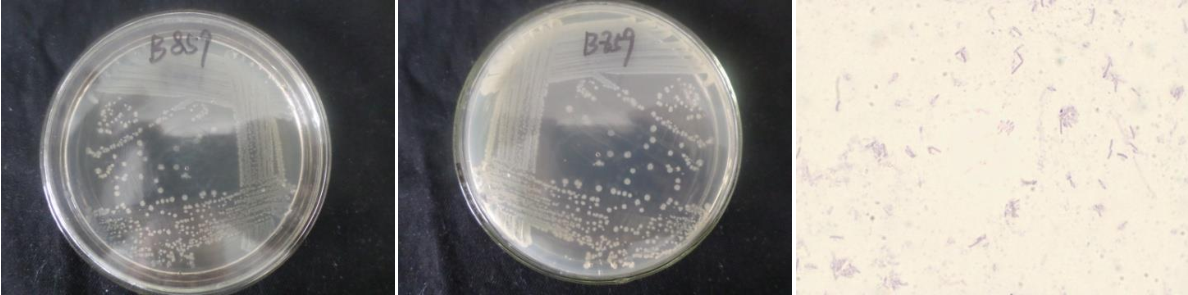

Loading...
| StrainNO | B859 |
| Classification | Bacillus |
| 16s rDNA sequence | TGCAAGTCGAGCGAATCTGAGGGAGCTTGCTCCCAAAGATTAGCGGCGGACGGGTGAGTAACACGTGGGTAACCTGCCTGTAAG ATTGGGATAACTCCGGGAAACCGGAGCTAATACCGGATAATATTTTGAACCGCATGGTTCAAAATTGAAAGACGGCTTTTGCTG TCACTTACAGATGGACCCGCGGCGCATTAGCTAGTTGGTGAGGTAACGGCTCACCAAGGCAACGATGCGTAGCCGACCTGAGAG GGTGATCGGCCACACTGGGACTGAGACACGGCCCAGACTCCTACGGGAGGCAGCAGTAGGGAATCTTCCGCAATGGACGAAAGT CTGACGGAGCAACGCCGCGTGAACGATGAAGGCCTTCGGGTCGTAAAGTTCTGTTGTTAGGGAAGAACAAGTACCAGAGTAACT GCTGGTACCTTGACGGTACCTAACCAGAAAGCCACGGCTAACTACGTGCCAGCAGCCGCGGTAATACGTAGGTGGCAAGCGTTG TCCGGAATTATTGGGCGTAAAGCGCGCGCAGGCGGTTTCTTAAGTCTGATGTGAAAGCCCACGGCTCAACCGTGGAGGGTCATT GGAAACTGGGGAACTTGAGTGCAGAAGAGGAGAGTGGAATTCCACGTGTAGCGGTGAAATGCGTAGAGATGTGGAGGAACACCA GTGGCGAAGGCGACTCTCTGGTCTGTAACTGACGCTGAGGCGCGAAAGCGTGGGGAGCGAACAGGATTAGATACCCTGGTAGTC CACGCCGTAAACGATGAGTGCTAAGTGTTAGAGGGTTTCCGCCCTTTAGTGCTGCAGCAAACGCATTAAGCACTCCGCCTGGGG AGTACGGTCGCAAGACTGAAACTCAAAGGAATTGACGGGGGCCCGCACAAGCGGTGGAGCATGTGGTTTAATTCGAAGCAACGC GAAGAACCTTACCAGGTCTTGACATCCTTCGCTACTTCTAGAGATAGAAGGTTCCCCTTCGGGGGACGAAGTGACAGGTGGTGC ATGGTTGTCGTCAGCTCGTGTCGTGAGATGTTGGGTTAAGTCCCGCAACGAGCGCAACCCTTGATCTTAGTTGCCAGCATTCAG TTGGGCACTCTAAGGTGACTGCCGGTGACAAACCGGAGGAAGGTGGGGATGACGTCAAATCATCATGCCCCTTATGACCTGGGC TACACACGTGCTACAATGGATGGTACAAAGGGCTGCAAGACTGCGAAGTCAAGCGAATCCCATAAAACCATTCTCAGTTCGGAT TGCAGGCTGCAACTCGCCTGCATGAAGCCGGAATCGCTAGTAATCGCGGATCAGCATGCCGCGGTGAATACGTTCCCGGGCCTT GTACACACCGCCCGTCACACCACGAGAGTTTGTAACACCCGAAGTCGGTGGGGTAACCGTAAGGAGCCAGCC |
| Strain Morphology Photos | |
| Morphological Description | Colony round;white;edge serrated;Edge slightly convex;concentric ring concave;convex in the middle;Many wrinkles;slippy;sticky;waxy;strain:Rod;having spore;Spores are intermediate |